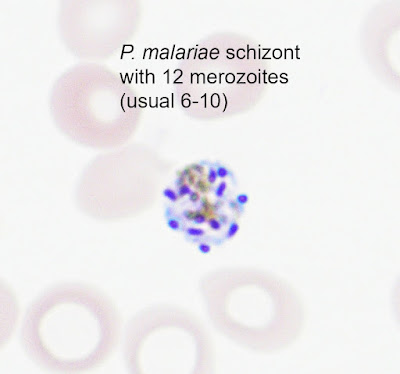

This week's case came through my lab awhile back and was beautifully captured in the following photographs by Emily Fernholz. The specimen is a Giemsa-stained thin blood film from a patient with travel to Botswana. What parasite is seen here?
Tuesday, March 29, 2022
Monday, March 28, 2022
Answer to Case 677
Answer to Parasite Case of the Week 677: Plasmodium malariae with classic band and schizont forms. There is also a hint of a basket form, and a nice collection of merozoites that recently burst out of an infected red blood cell. Note that the infected cells are smaller than the uninfected neighboring cells, which is classic for this species. Thank you for all of the great comments!
Tuesday, March 15, 2022
Case of the Week 676
This week's case is generously donated by Dr. Adrienne Showler. The following was passed in stool by an 'adventurous eater', who regularly enjoys raw fish dishes, and also has tried raw beef and pork dishes in the United States. He reports passing similar objects on 4 separate occasions, and the length of each was between 1 and 3 feet. Unfortunately he didn't collect the samples (!), so we only have these photographs:
Likely identification?
Sunday, March 13, 2022
Answer to Case 676
Answer to the Parasite Case of the Week 676: Cestode, most likely Diphyllobothrium/Dibothriocephalus/Adenocephalus species. The CDC DPDx webpage on diphyllobothriasis explains how some of the names have changed for this group of tapeworms.
Unfortunately the specimen was not submitted to the laboratory and we therefore can't fully examine it. However, central uterine structure seen in the photo below is consistent with an adult tapeworm of the family Diphyllobothriidae:
Thanks again to Dr. Showler for contributing this case!Sunday, March 6, 2022
Case of the Week 675
This week's case was donated by Dr. Paul Valenstein, and it is a beautiful example of an uncommon finding. It is an eyelid biopsy from a 6-year-old African child.
Diagnosis?
Saturday, March 5, 2022
Answer to Case 675
Answer to the Parasite Case of the Week 675: Coenurosis, a tapeworm infection with the larval form of coenurus-forming Taenia species, such as T. multiceps (the most commonly implicated species), T. serialis, T. brauni, and T. glomeratus.
Some of you noted the resemblance of this tissue infection with cysticercosis. That makes sense since human cysticercosis is due to the related cestode, Taenia solium. The primary difference is the presence of a single protoscolex in cysticercosis, vs. multiple protoscoleces in coenurosis.
Here is my approach to the diagnosis:
- We can first tell this is a cestode by the presence of the calcareous corpuscles (nice call Idzi!)
- The presence of a thin eosinophilic tegument and loose stroma is also supportive of this being a cestode.
- We can further narrow this down to a larval cestode based on its location (within tissue) and cystic appearance. The cystic appearance helps us further narrow down our differential to cystic echinococcosis, cysticercosis, and coenurosis.
- The presence of multiple protoscoleces allows us to rule out cysticercosis (which only has a single protoscolex), bringing us to a differential diagnosis of just 2 cestode infections, cystic echinococcosis and coenurosis.
- Finally, we can differentiate cystic echinococcus from coenurosis by the appearance of their protoscoleces. Taenia spp. protoscoleces have a convoluted spiral canal, whereas Echinococcus spp. do not.
Tuesday, March 1, 2022
Case of the Week 674
This week's case is courtesy of Dr. Charlie Huskins, one of our pediatric ID physicians. The parents of his patient found the following bug in their home and were concerned that it might be a disease vector. They are concerned that it might have bitten their child, as they have identified a potential 'bite' mark.
Of note, the family lives in the midwestern United States and has no history of recent travel.
What is the general identification of this bug? Is there any concern for disease transmission?
.jpg)
.jpg)
.jpg)
.jpg)
.jpg)
.jpg)
.jpg)